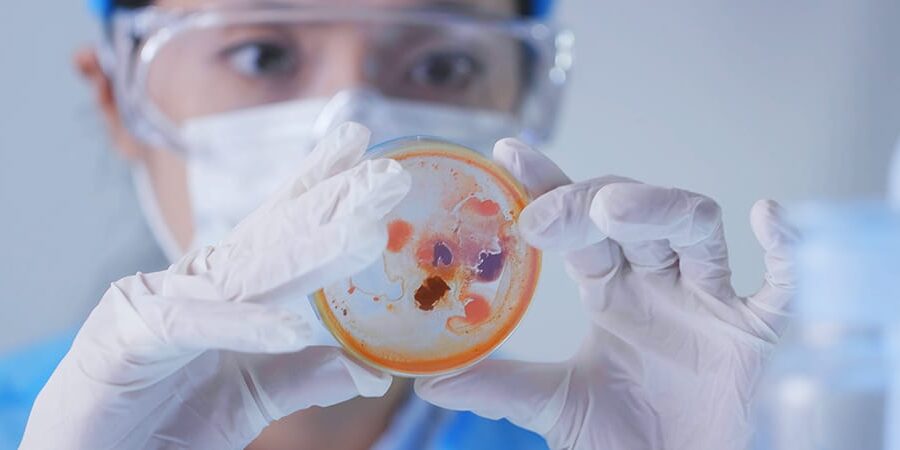
Beyond Accounting advice Claiming Research And Development Tax Credits In Ireland

Filter

Why You Can’t Execute A Plan Without Good Data (Rockefeller Habits 2.0)
Why You Can’t Execute A Plan Without Good Data (Rockefeller Habits 2.0)

Tech Company Valuations Have Changed, So What Comes Next?
Tech Company Valuations Have Changed, So What Comes Next?

Use The Power Of Singular Focus to Build Momentum (Rockefeller Habits 2.0)
Use The Power Of Singular Focus to Build Momentum (Rockefeller Habits 2.0)

The 10 Rockefeller Habits That Will Help Your Business Flourish
The 10 Rockefeller Habits That Will Help Your Business Flourish

Why It’s Important That Your Business Makes A Profit
Why It’s Important That Your Business Makes A Profit

The Advantages And Benefits Of Outsourced Accounting
The Advantages And Benefits Of Outsourced Accounting

Is Your Business Financially Prepared For Economic Uncertainty?
Is Your Business Financially Prepared For Economic Uncertainty?

How To Calculate Markups And Margins (With Formulas)
How To Calculate Markups And Margins (With Formulas)

How To Set Your Rates Or Pricing In A Service Business
How To Set Your Rates Or Pricing In A Service Business

Y Combinator Accelerator: What Is It And Should You Apply?
Y Combinator Accelerator: What Is It And Should You Apply?

Is A Startup Accelerator The Next Step For Your Irish Business?
Is A Startup Accelerator The Next Step For Your Irish Business?

The Top Seven Habits Of Highly Effective Business People
The Top Seven Habits Of Highly Effective Business People

Four Ways To Prepare Your Company For A Future Sale
Four Ways To Prepare Your Company For A Future Sale

Small Benefit Exemption: Give Employees Up To €1,500 Tax-Free In 2026
Small Benefit Exemption: Give Employees Up To €1,500 Tax-Free In 2026

How A One-Page Strategic Plan (OPSP) Helps You Achieve Growth (Rockefeller Habits 2.0)
How A One-Page Strategic Plan (OPSP) Helps You Achieve Growth (Rockefeller Habits 2.0)

My Future Fund Launches 1st January 2026 – What Employers Need To Know
My Future Fund Launches 1st January 2026 – What Employers Need To Know

Top Tax-Saving Tips For Filing Your Form 11 Income Tax Return
Top Tax-Saving Tips For Filing Your Form 11 Income Tax Return

Understanding The 7 Layers That Differentiate Your Business (Rockefeller Habits 2.0)
Understanding The 7 Layers That Differentiate Your Business (Rockefeller Habits 2.0)

Beyond Bank Loans: Sources Of Alternative Finance For Irish Businesses
Beyond Bank Loans: Sources Of Alternative Finance For Irish Businesses

Is The NDRC’s Accelerator The Next Move For Your Early-Stage Tech Startup?
Is The NDRC’s Accelerator The Next Move For Your Early-Stage Tech Startup?

The End Of Easy SaaS: What Irish Founders Must Know Before Their Next Fundraise
The End Of Easy SaaS: What Irish Founders Must Know Before Their Next Fundraise

Audit Exemption Rules Changed For Small & Micro Companies In Ireland
Audit Exemption Rules Changed For Small & Micro Companies In Ireland

The Best Business Strategies Start With Knowing Your Core (Rockefeller Habits 2.0)
The Best Business Strategies Start With Knowing Your Core (Rockefeller Habits 2.0)

How Much Cash Should A Business Have In Reserve?
How Much Cash Should A Business Have In Reserve?

12 Stress-Busting Secrets To Ease The Heavy Weight Of Running A Business
12 Stress-Busting Secrets To Ease The Heavy Weight Of Running A Business

Technology Investment In Ireland 2024-25: Finding Funding Success
Technology Investment In Ireland 2024-25: Finding Funding Success

From Kitchen Table To Boardroom – When Should You Incorporate Your Business?
From Kitchen Table To Boardroom – When Should You Incorporate Your Business?

Some Handy Keyboard Shortcuts For Xero
Some Handy Keyboard Shortcuts For Xero

Raising Funding From Angels And VCs – What’s Changed For Irish ScaleUps
Raising Funding From Angels And VCs – What’s Changed For Irish ScaleUps

What Does It Take To Be A Successful Manager? (Rockefeller Habits 2.0)
What Does It Take To Be A Successful Manager? (Rockefeller Habits 2.0)

Integrate Xero & Revolut BillPay For Easy Payments
Integrate Xero & Revolut BillPay For Easy Payments

Top Funding Supports Available From Enterprise Ireland
Top Funding Supports Available From Enterprise Ireland

Ireland Needs More Entrepreneurs; This Simple Solution Can Make That Happen
Ireland Needs More Entrepreneurs; This Simple Solution Can Make That Happen

Switching Accountant for 2025? What You Should Know Before You Choose
Switching Accountant for 2025? What You Should Know Before You Choose

How To Ensure Your Teams Are Your Best Asset (Rockefeller Habits 2.0)
How To Ensure Your Teams Are Your Best Asset (Rockefeller Habits 2.0)

The Tax Benefits Of Running A Limited Company in Ireland
The Tax Benefits Of Running A Limited Company in Ireland

How The Right Leaders Help You Scale (Rockefeller Habits 2.0)
How The Right Leaders Help You Scale (Rockefeller Habits 2.0)

Top Habits That Will Enable Your Business To Scale (Rockefeller Habits 2.0)
Top Habits That Will Enable Your Business To Scale (Rockefeller Habits 2.0)

Are Your Workers Employees Or Contractors, And Why Does It Matter?
Are Your Workers Employees Or Contractors, And Why Does It Matter?

An Easy 4-Step Strategy To Drive Profit In Your Business
An Easy 4-Step Strategy To Drive Profit In Your Business

The Green Supports Helping Irish Companies To Put Sustainability First
The Green Supports Helping Irish Companies To Put Sustainability First

Locate Your Business In Enterprise-Friendly Ireland
Locate Your Business In Enterprise-Friendly Ireland

Selling Your Company? Reduce Your CGT With A Holding Company
Selling Your Company? Reduce Your CGT With A Holding Company

SaaS Success: How Easy Is It To Scale A Global Tech Startup?
SaaS Success: How Easy Is It To Scale A Global Tech Startup?

Our Top Pension Tips Reveal The Path To A Comfortable Retirement
Our Top Pension Tips Reveal The Path To A Comfortable Retirement

What Is A Professional Services Company According To Irish Revenue?
What Is A Professional Services Company According To Irish Revenue?

The Insider Secrets That Will Transform Your Investment Strategy
The Insider Secrets That Will Transform Your Investment Strategy

Stress-Free Business Planning With LivePlan (Including Export To Excel Feature)
Stress-Free Business Planning With LivePlan (Including Export To Excel Feature)

How Much Should My Company Accountant Cost In Ireland?
How Much Should My Company Accountant Cost In Ireland?

Clear Warehoused Tax With A Phased Payment Arrangement (PPA)
Clear Warehoused Tax With A Phased Payment Arrangement (PPA)

10 Ways To Unlock Real-Time Accounting Strategies For Financial Success
10 Ways To Unlock Real-Time Accounting Strategies For Financial Success

Is Ireland As Unicorn-Friendly As It Could, Or Should, Be?
Is Ireland As Unicorn-Friendly As It Could, Or Should, Be?

Unleashed Software Helps You Unlock The Value Of Your Inventory
Unleashed Software Helps You Unlock The Value Of Your Inventory

Surplus Cash On The Balance Sheet? Don’t Expect A Return From Your Irish Bank
Surplus Cash On The Balance Sheet? Don’t Expect A Return From Your Irish Bank

Enhanced Reporting Requirements (ERR): What You Need To Know In 2024
Enhanced Reporting Requirements (ERR): What You Need To Know In 2024

How Do You Retire From A Business? Options For Irish Company Owner-Directors
How Do You Retire From A Business? Options For Irish Company Owner-Directors

Recover 25% Of Your Innovation Costs With The R&D Tax Credit
Recover 25% Of Your Innovation Costs With The R&D Tax Credit

Supports For Irish Businesses Affected By The Crisis In Ukraine
Supports For Irish Businesses Affected By The Crisis In Ukraine

How Enterprise Ireland Can Help You Scale Your Business
How Enterprise Ireland Can Help You Scale Your Business

Horizon Europe Offers Funding Opportunities For Innovative Irish Businesses
Horizon Europe Offers Funding Opportunities For Innovative Irish Businesses

Big Tax Debts? Liquidation May Not Be The Best Option
Big Tax Debts? Liquidation May Not Be The Best Option

Do You Know About These Important Changes Protecting Tips/Gratuities?
Do You Know About These Important Changes Protecting Tips/Gratuities?

Reduce Your Capital Gains Tax Liability With Entrepreneur Relief
Reduce Your Capital Gains Tax Liability With Entrepreneur Relief

Do You Issue Shares To Employees? Your Reporting Obligations Have Changed
Do You Issue Shares To Employees? Your Reporting Obligations Have Changed

What’s The Perfect Size For A Successful Business?
What’s The Perfect Size For A Successful Business?

Scaling Up? Incentivise Key Employees With Growth Shares
Scaling Up? Incentivise Key Employees With Growth Shares

Why You Should Create A Monthly Budget For Your Business
Why You Should Create A Monthly Budget For Your Business

Xero Analytics Gets You Closer To Your Business Finances
Xero Analytics Gets You Closer To Your Business Finances

Working Remotely – Tax Relief Available For Employees in Ireland
Working Remotely – Tax Relief Available For Employees in Ireland

Manage Your Business More Effectively With Monday.com
Manage Your Business More Effectively With Monday.com

How To Write A Great Business Plan
How To Write A Great Business Plan

This One Tactic Will Increase The Value Of Your Business
This One Tactic Will Increase The Value Of Your Business

Xero – Return Of Live Bank Feeds & Other News
Xero – Return Of Live Bank Feeds & Other News

Investors Get 40% Tax Benefit With Updated EIIS Scheme
Investors Get 40% Tax Benefit With Updated EIIS Scheme

Track Time, Tasks & Expenses With Xero Projects
Track Time, Tasks & Expenses With Xero Projects

Should You Become An Irish B Corporation?
Should You Become An Irish B Corporation?

SaaS Company Metrics – What To Track And How
SaaS Company Metrics – What To Track And How

A Career In Accounting – Myth vs Reality!
A Career In Accounting – Myth vs Reality!

How To Get Started On Your Digitalisation Journey
How To Get Started On Your Digitalisation Journey

What Is A Productivity Suite And Why Should You Care?
What Is A Productivity Suite And Why Should You Care?

Why Upskilling & Knowledge Transfer Should Be A Business Priority
Why Upskilling & Knowledge Transfer Should Be A Business Priority

Payment Habits Are Changing Across The Eurozone
Payment Habits Are Changing Across The Eurozone

Optimising Your Business Processes With Digitalisation
Optimising Your Business Processes With Digitalisation

Moving To An Enterprise-Level Accounting System
Moving To An Enterprise-Level Accounting System

Green Supports And Funding For Irish Businesses
Green Supports And Funding For Irish Businesses

What Is QuickBooks Online And Does It Work In Ireland?
What Is QuickBooks Online And Does It Work In Ireland?

A Skilled Bookkeeper Will Save You Time & Money
A Skilled Bookkeeper Will Save You Time & Money

An Easy Way To Manage Expenses & Spending With Xero
An Easy Way To Manage Expenses & Spending With Xero

Goodbye Timesheets; Say Hello To Chargeable Hours
Goodbye Timesheets; Say Hello To Chargeable Hours

Business As A Force For Good & Companies With Purpose
Business As A Force For Good & Companies With Purpose

Predictions For A Post-COVID Business World
Predictions For A Post-COVID Business World

Ireland’s Legal Limited Liability Partnership And Its Benefits
Ireland’s Legal Limited Liability Partnership And Its Benefits

The New One-Stop Shop (OSS) For European VAT
The New One-Stop Shop (OSS) For European VAT

Food Delivery Apps – The Pros and Cons For Restaurants
Food Delivery Apps – The Pros and Cons For Restaurants

How To Build A Solid Accounting System Around Your Ecommerce Site
How To Build A Solid Accounting System Around Your Ecommerce Site

How Much Should Bookkeeping Cost Your Business?
How Much Should Bookkeeping Cost Your Business?

What To Do If Irish Revenue Selects Your Business For Audit
What To Do If Irish Revenue Selects Your Business For Audit

SBCI Is Driving Innovation And Competition In Business Loans
SBCI Is Driving Innovation And Competition In Business Loans

VAT Changes For Irish Businesses Trading With The UK
VAT Changes For Irish Businesses Trading With The UK

Three Key Metrics To Track If You Run A Restaurant
Three Key Metrics To Track If You Run A Restaurant

Streamlined, Paperless Filing On The New CORE System
Streamlined, Paperless Filing On The New CORE System

Getting The Right Financial Insights For Your MSP Company
Getting The Right Financial Insights For Your MSP Company

How I Grew My Business Using Content Marketing
How I Grew My Business Using Content Marketing

Better Cash Flow Forecasting And Futrli
Better Cash Flow Forecasting And Futrli
Claiming Research And Development Tax Credits In Ireland
Claiming Research And Development Tax Credits In Ireland

What You Need To Know About Business Process As A Service (BPaaS)
What You Need To Know About Business Process As A Service (BPaaS)

Why Some SaaS Companies Are Thriving In A Niche
Why Some SaaS Companies Are Thriving In A Niche

How To Manage Your Business More Proactively
How To Manage Your Business More Proactively

Buying And Selling A Professional Services Company
Buying And Selling A Professional Services Company

Why You Need To Know The Difference Between Direct Costs And Indirect Costs
Why You Need To Know The Difference Between Direct Costs And Indirect Costs

Exciting Developments From SaaS Companies At SaaStock 2019
Exciting Developments From SaaS Companies At SaaStock 2019

6 Things That Tech Companies Love About Using Xero
6 Things That Tech Companies Love About Using Xero

Who Does The Accounting In Your Owners’ Management Company?
Who Does The Accounting In Your Owners’ Management Company?

Why Xero Is A Smart Investment For Not-For-Profit And Membership Organisations
Why Xero Is A Smart Investment For Not-For-Profit And Membership Organisations

Top 4 Trends To Watch In Retail And Hospitality Right Now
Top 4 Trends To Watch In Retail And Hospitality Right Now

Ditch Legacy POS And Enjoy Easy Xero Integration With Lightspeed
Ditch Legacy POS And Enjoy Easy Xero Integration With Lightspeed

Are You Still Getting Stung By Bad Currency Exchange Rates And Fees?
Are You Still Getting Stung By Bad Currency Exchange Rates And Fees?

Challenger Banks Are Revolutionising How You Do Banking
Challenger Banks Are Revolutionising How You Do Banking

Enjoy Serious Tax Savings By Making Pension Contributions
Enjoy Serious Tax Savings By Making Pension Contributions
Beyond And CBE Team Up To Create A PixelPoint Integration Solution For Xero!
Beyond And CBE Team Up To Create A PixelPoint Integration Solution For Xero!

Brexit Is An Opportunity For Irish SMEs To Get Access To Soft Loans
Brexit Is An Opportunity For Irish SMEs To Get Access To Soft Loans

How To Use Timesheets For More Accurate Invoicing
How To Use Timesheets For More Accurate Invoicing

Automate Expense Claims With The Xero Expenses App
Automate Expense Claims With The Xero Expenses App

Spark Crowdfunding Offers A New Way For SMEs To Raise Equity
Spark Crowdfunding Offers A New Way For SMEs To Raise Equity

Chaser – The Credit Control App That Chases Debtors For You
Chaser – The Credit Control App That Chases Debtors For You

What You Need To Know About PAYE Modernisation Coming On 1st January 2019
What You Need To Know About PAYE Modernisation Coming On 1st January 2019

How To Conduct A Company Valuation
How To Conduct A Company Valuation

Is Financial Trauma Hurting Your Pension Savings?
Is Financial Trauma Hurting Your Pension Savings?

Take Back The Reins With A Mid-Year Review
Take Back The Reins With A Mid-Year Review

4 Powerful Books To Boost Your Business Brain
4 Powerful Books To Boost Your Business Brain

Association Of Chartered Accountants: Tips For Exam Success!
Association Of Chartered Accountants: Tips For Exam Success!

Keeping Key Performance Indicators (KPIs) Simple
Keeping Key Performance Indicators (KPIs) Simple

Strategic Outsourcing Gives You Room To Grow
Strategic Outsourcing Gives You Room To Grow

AutoEntry Puts An End To Manual Data Entry!
AutoEntry Puts An End To Manual Data Entry!

Boost Your Ecommerce Game With Shopify And Xero
Boost Your Ecommerce Game With Shopify And Xero

CGT Retirement Relief – Disposing Of Your Business Assets
CGT Retirement Relief – Disposing Of Your Business Assets

Xero – Designed To Integrate With Your Business Systems
Xero – Designed To Integrate With Your Business Systems

The True Cost Of Third Level Education And How To Save For It
The True Cost Of Third Level Education And How To Save For It

Form 11 – A Wise Time To Make That Pension Contribution
Form 11 – A Wise Time To Make That Pension Contribution

When The Quick Fix Pension Doesn’t Go As Planned
When The Quick Fix Pension Doesn’t Go As Planned

Different Types Of Life Assurance Cover Explained
Different Types Of Life Assurance Cover Explained

How We Focus On Going Beyond Customer Service
How We Focus On Going Beyond Customer Service

Effective Credit Control In Business
Effective Credit Control In Business

The Benefits Of Xero Accounting Software
The Benefits Of Xero Accounting Software

Leasing And Invoice Financing In Ireland
Leasing And Invoice Financing In Ireland

How To Convert To Xero Accounting Software
How To Convert To Xero Accounting Software

Accounting Solutions For Small Business – Sage vs Xero
Accounting Solutions For Small Business – Sage vs Xero

How To Succeed With Your New Business
How To Succeed With Your New Business

Modern Accounting – Staying Relevant!
Modern Accounting – Staying Relevant!

Xero Bank Feeds In Ireland (BOI, AIB, Ulster)
Xero Bank Feeds In Ireland (BOI, AIB, Ulster)

Better Forecasting And Insights With Spotlight!
